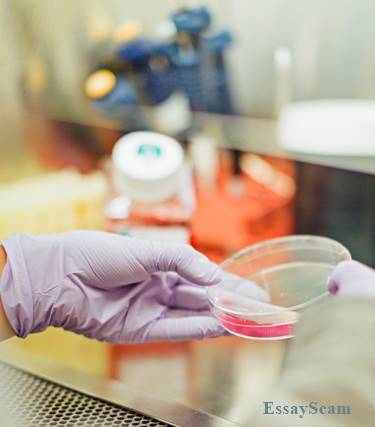
University Lab

Collegedegree 9 | - Freelance Writer
Jul 30, 2018 | #1
Most students are familiar with the academic form of essay writing. You know what I am talking about. The kinds of essays that rely on personal opinions, research, or public opinions. The types of essays that don't really require much analysis, just an understanding of the subject matter. A lab report on the other hand, goes deeper into a subject matter because it deals with observational analysis of a given subject. It is a form of writing that is more applicable in a professional setting but is a writing skill that can only be developed over time. Beginning with class science experiments, students already have their analytical writing skills laid out for them. Let's look at the facts that support the importance of lab report writing in a student's quest to learn how to write professional papers.
 Lab Report writing all starts with the development of a hypothesis. A hypothesis, in academic writing, is equivalent to the thesis statement. However, a hypothesis is not based on a public discussion but rather, the possible outcome of a specific set actions that result in an observation- based result.
Lab Report writing all starts with the development of a hypothesis. A hypothesis, in academic writing, is equivalent to the thesis statement. However, a hypothesis is not based on a public discussion but rather, the possible outcome of a specific set actions that result in an observation- based result.
These observations are in turn based upon a series of related actions performed in a chronological manner. Lab Report writing forces a student to be careful instead of haphazard in his actions. He becomes conscious of the fact that one false move on his part will result in an altered outcome for his experiment or worse, a failed experiment, and we all know that students hate to have to start over on anything right?
When completing a lab report, every step and result of the ongoing experiment needs to be recorded for future reference and information collation. Only the actual results, as it occurs in the experiment may be logged for these purposes. There is no room for exaggeration, there is no room to skip information. When a student becomes careless, the experiment fails. That is why students become more observant and diligent when it comes to note taking. They begin to understand the importance of accuracy in note taking through the experiment phase of the lab report development. They learn to skip the emotions in writing, reject bias in presentations, simply, tell the facts as it is in relation to the experiment and its results.
When completing a lab report based on experimentation techniques, a student needs to use more skills to complete his work. These skills are:
1. Observational - after developing the thesis statement, the student must then observe the results of his experiment for analysis purposes;
2. Analytical - based upon the observational results a comparison of the hypothetical statement and observational results will be required. The analysis of which will result in the logical reasoning that will prove or disprove the thesis statement.
3. Logical Reasoning - the conclusion of the lab report. It delivers a deep analysis and explanation of why the results where what they are and what it means in terms of relevance to the hypothesis and final results.
As a student progresses in his education, and upon his entry into professional life, the student will begin to understand the importance of teamwork and how these principles were instilled in him during the group experimentation work in his early science classes. The manner by which the students have to work on their parts of the experiment, submit it to the group leader when they are done, and then come together again to double check the results of the experiment all become part and parcel of the student's professional life. Thus, lab report writing helps the student learn how to work with a team to produce accurate results at an early stage in his academic life.
Academic writing is part and parcel of regular learning. However, appropriate attention should also be paid to lab report writing in elementary and high school levels of learning because it helps students learn how to write in a more analytical and logical manner when compared to writing essay based solely on reading materials written by other people for an observation or opinion.
Students Learn Organizational Skills
Lab Report writing all starts with the development of a hypothesis. A hypothesis, in academic writing, is equivalent to the thesis statement. However, a hypothesis is not based on a public discussion but rather, the possible outcome of a specific set actions that result in an observation- based result.
Lab Report writing all starts with the development of a hypothesis. A hypothesis, in academic writing, is equivalent to the thesis statement. However, a hypothesis is not based on a public discussion but rather, the possible outcome of a specific set actions that result in an observation- based result.These observations are in turn based upon a series of related actions performed in a chronological manner. Lab Report writing forces a student to be careful instead of haphazard in his actions. He becomes conscious of the fact that one false move on his part will result in an altered outcome for his experiment or worse, a failed experiment, and we all know that students hate to have to start over on anything right?
Students Learn to See Things as They Truly Are
When completing a lab report, every step and result of the ongoing experiment needs to be recorded for future reference and information collation. Only the actual results, as it occurs in the experiment may be logged for these purposes. There is no room for exaggeration, there is no room to skip information. When a student becomes careless, the experiment fails. That is why students become more observant and diligent when it comes to note taking. They begin to understand the importance of accuracy in note taking through the experiment phase of the lab report development. They learn to skip the emotions in writing, reject bias in presentations, simply, tell the facts as it is in relation to the experiment and its results.
Brain Development
When completing a lab report based on experimentation techniques, a student needs to use more skills to complete his work. These skills are:
1. Observational - after developing the thesis statement, the student must then observe the results of his experiment for analysis purposes;
2. Analytical - based upon the observational results a comparison of the hypothetical statement and observational results will be required. The analysis of which will result in the logical reasoning that will prove or disprove the thesis statement.
3. Logical Reasoning - the conclusion of the lab report. It delivers a deep analysis and explanation of why the results where what they are and what it means in terms of relevance to the hypothesis and final results.
Learning to Work as a Team
As a student progresses in his education, and upon his entry into professional life, the student will begin to understand the importance of teamwork and how these principles were instilled in him during the group experimentation work in his early science classes. The manner by which the students have to work on their parts of the experiment, submit it to the group leader when they are done, and then come together again to double check the results of the experiment all become part and parcel of the student's professional life. Thus, lab report writing helps the student learn how to work with a team to produce accurate results at an early stage in his academic life.
Academic writing is part and parcel of regular learning. However, appropriate attention should also be paid to lab report writing in elementary and high school levels of learning because it helps students learn how to write in a more analytical and logical manner when compared to writing essay based solely on reading materials written by other people for an observation or opinion.
